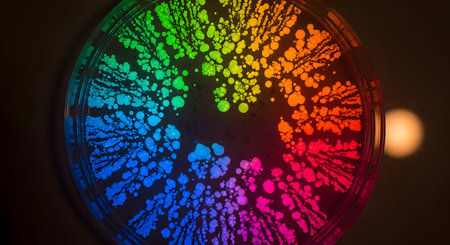
Petri dish with colorful bacteria; rainbow colonies; scientific art; microbiology culture; vibrant growth on dark backgroundの素材

素材 - Petri dish with colorful bacteria; rainbow colonies; scientific art; microbiology culture; vibrant growth on dark background
作品情報
Petri dish with colorful bacteria; rainbow colonies; scientific art; microbiology culture; vibrant growth on dark background
- ID:256413860
- 作品種別:
- 作者名:Md Asif Shahnaoaz
キーワード
- abstract
- art
- bacteria
- biology
- biotechnology
- black
- bright
- circular
- close up
- colonies
- colorful
- conceptual
- contrast
- culture
- dark background
- design
- development
- discovery
- education
- experiment
- glowing
- growth
- health
- illuminated
- innovation
- laboratory
- learning
- magnified
- medical
- medical research
- microbiology
- microorganism
- microscopic
- organism
- overhead
- pattern
- petri dish
- rainbow
- research
- round
- science
- spectrum
- technology
- texture
- top view
- vibrant
- visual
類似作品
close-up of sci...
Laboratory petr...
Close up of col...
Close up view r...
close-up of vib...
Colorful variet...
Top view of a p...
petri dish with...
Fresh donut ser...
Microscopic vie...
Colorful variet...
Detailed close-...
Microscopic vie...
Abstract backgr...
A cluster of va...
petri dish with...
atom science ch...
Macro close up ...
petri dishes wi...
A plate with a ...
microbial cultu...
petri dish fill...
close-up of a p...
This striking i...
Petri dish with...
Bacterial colon...
microbial cultu...
petri dish with...
microbial cultu...
Close up of bac...
close-up of pet...
Scientist holdi...
close-up of sci...
bacteria colony...
Colorful variet...
top view of a p...
Vibrant represe...
petri dish with...
microbial cultu...
petri dish with...
A vibrant petri...
Mixed of bacter...
Diverse colorfu...
Scientific imag...
3d rendering. M...
This vivid abst...
Petri dishes di...
Colorful microb...
Macro close up ...